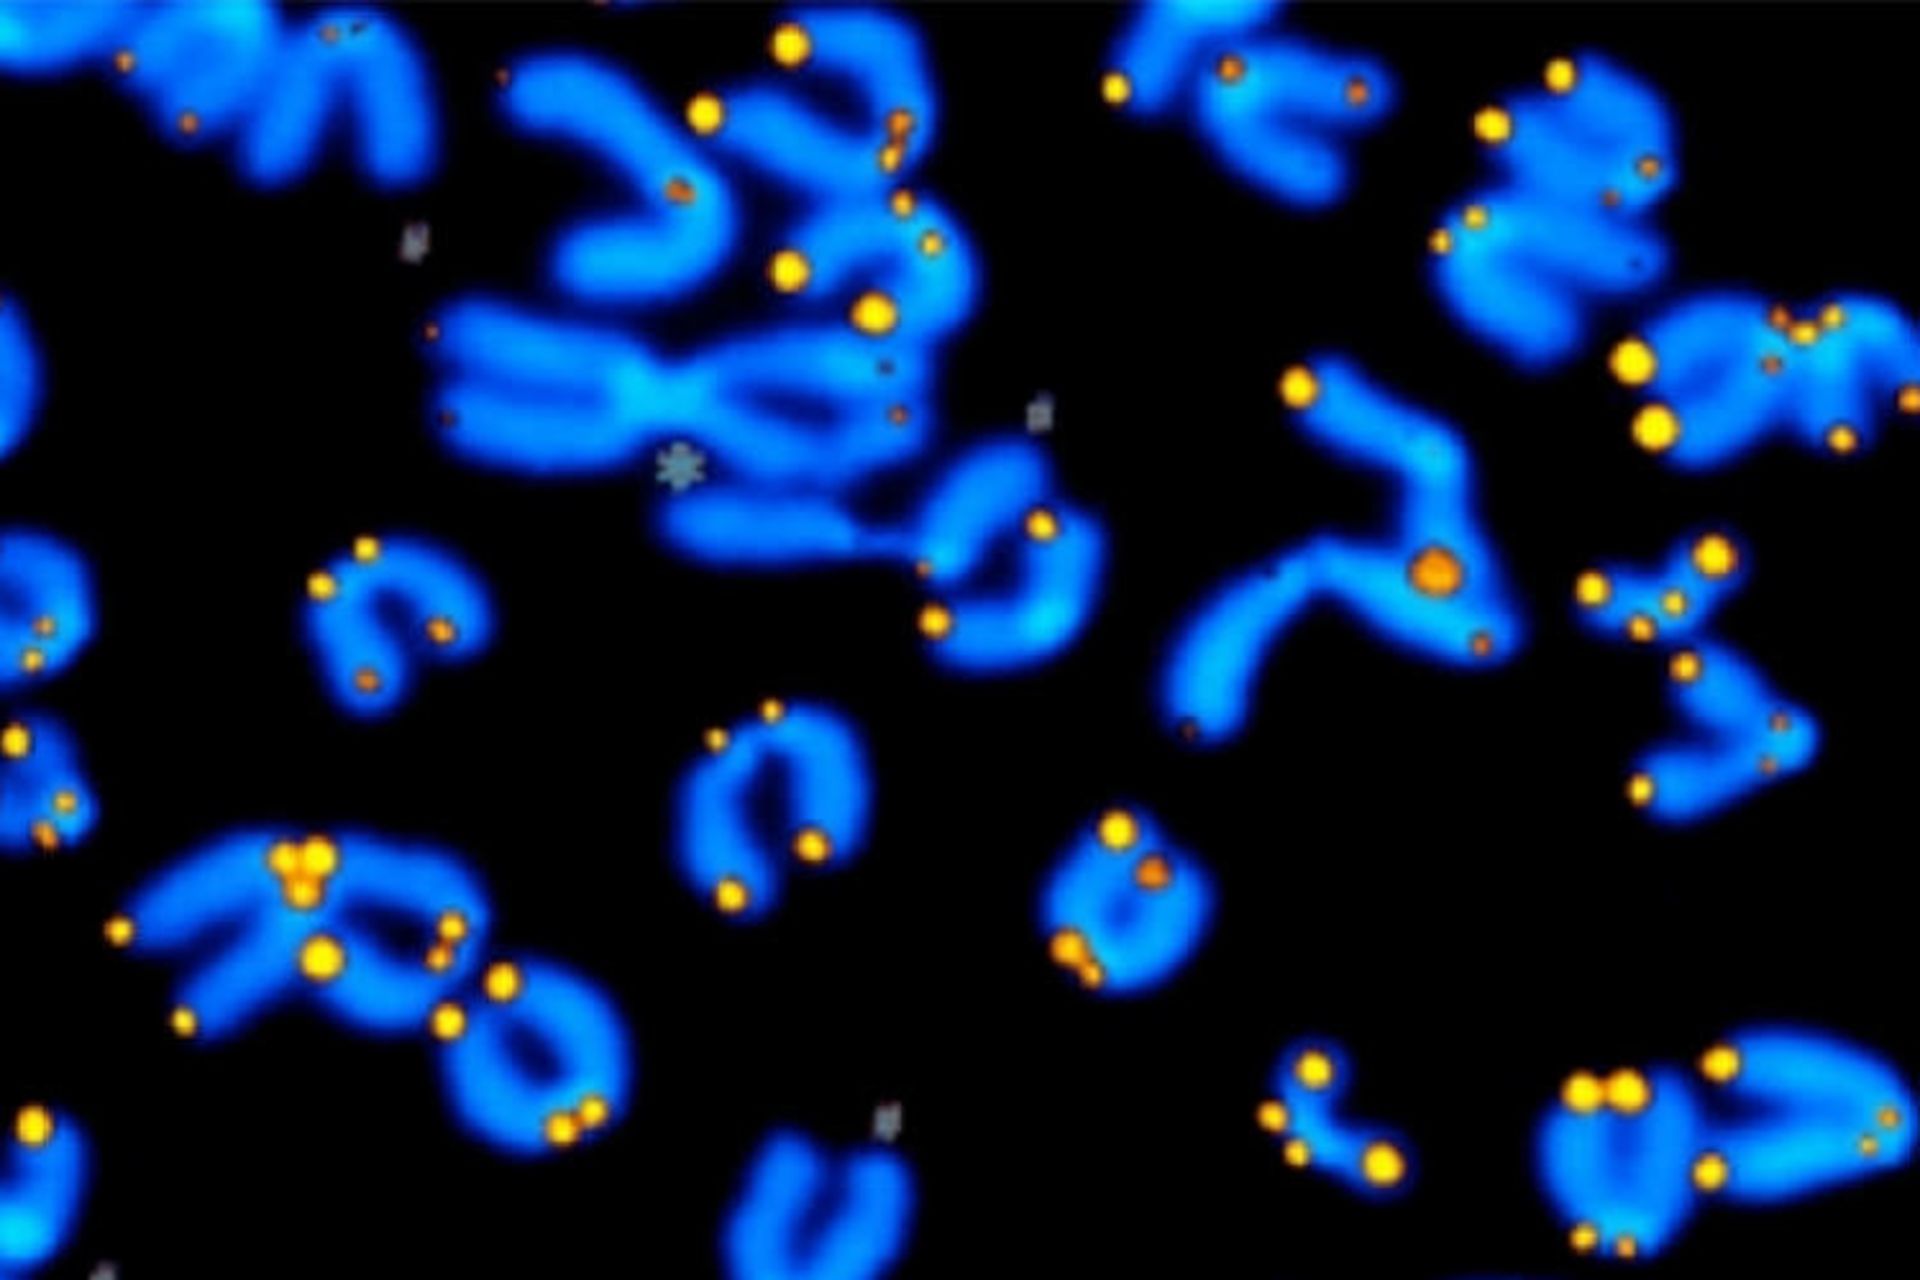

راز پنهان جاودانگی آنزیم تلومراز و آرزوی بشر برای عمر طولانیتر
اخیرا مرحلهی مهمی در چرخه کاتالیستی آنزیم تلومراز کشف شده است. این چرخه کاتالیستی توانایی آنزیم تلومراز انسان را برای ساخت DNA تعیین میکند. تحقیقات آزمایشگاه پروفسور جولیان چن در دانشکدهی علوم مولکولی دانشگاه آریزونا اخیرا مورد مهمی را در چرخه کاتالیزوری آنزیم تلومراز آشکار کرده است. این چرخهی کاتالیسیتی توانایی آنزیم تلومراز انسانی را برای ساخت تکرارهای DNA (قطعات خاص DNA با طول شش نوکلئوتید) در انتهای کروموزمها تعیین میکند و بنابراین نامیرایی سلولها را کنترل میکند. درک مکانیسم پشت صحنهی عمل آنزیم تلومراز میتواند گامی در جهت درمانهای ضد پیری جدید باشد. در شکل زیر آنزیم تلومراز و تلومرهای مرتبط با کروموزوم نشان داده شده است.

آنزیم تلومراز و تلومرهای کروموزوم
سلولهای معمولی انسان فانی هستند و نمیتوانند برای همیشه خود را بازسازی کنند. همانطور که لئونارد هایفلیک در نیم قرن پیش نشان داده است، سلولهای انسانی دارای طول عمر تکثیر محدودی هستند و سلولهای پیرتر زودتر از سلولهای جوان به این محدوده میرسند. این محدودهی هایفلیک از طول عمر سلولی مستقیما مرتبط با تعداد تکرارهای قطعه DNA خاصی است که در انتهای کروموزمهای حامل مواد ژنتیکی قرار گرفته است.
این تکرارهای DNA بخشی از ساختارهای پوششی حفافظتی است که تلومر نامیده میشوند. تلومرها انتهای کروموزومها را از نوآراییهای ناخواسته و بیجای DNA که موجب بیثباتی ژنوم میشوند، محافظت میکنند. با هر بار تقسیم سلول، DNA تلومری کوتاهتر میشود و در نهایت به جایی میرسد که دیگر قادر به حفاظت از انتهاهای کروموزمها نیست. این کاهش پیوسته در طول تلومر مانند یک ساعت مولکولی عمل میکند که دارای شمارش معکوسی تا زمان رسیدن به انتهای رشد سلول است. کاهش توانایی رشد سلول بهطور قوی با فرایند پیر شدن مرتبط است و کاهش جمعیت سلولها مستقیما در ایجاد ضعف، بیماری و نارسایی اعضا نقش دارد.

انیمیشن نشاندهندهی چرخهی واکنش آنزیم تلومراز
در مقابل فرایند کوتاه شدن تلومرها، آنزیم تلومراز قرار دارد که بهطور منحصربهفردی فرایند پیر شدن سلول را به تأخیر میاندازد و حتی موجب معکوس شدن آن میشود. تلومراز با افزایش طول تلومرها و افزودن تکرارهای DNA از دست رفته با فرایند پیر شدن سلول مبارزه میکند و بهطور موثری موجب افزایش طول عمر سلول میشود.
تلومرازها طول تلومرها را با سنتر مکرر قطعات شش نوکلئوتیدی از DNA افزایش میدهند (با اضافه کردن توالی GGTTAG در انتهای کروموزومها از روی الگوی RNA که درون خود آنزیم قرار گرفته است). با این حال فعالیت آنزیم تلومراز برای بازیابی کامل تکرارهای از دست رفتهی DNA تلومریک کافی نیست و نمیتواند کاملا فرایند پیر شدن سلولی را متوقف سازد. کوتاه شدن تدریجی تلومرها روی قابلیت تکثیر سلولهای بنیادی بالغ انسانی (سلولهایی که موجب نوسازی بافتها و اعضای پیر در بدن میشوند) تأثیر منفی میگذارد. فعالیت تلومراز در سلول بنیادی بالغ صرفا موجب کاهش دادن سرعت شمارش معکوس ساعت ملکولی میشود و بهطور کامل نمیتواند موجب نامیرایی سلولها شود. بنابراین سلولهای بنیادی بالغ در انسان سالخورده بهعلت کاهش یافتن طول تلومر ضعیف میشوند که این امر موجب افزایش زمان بهبود زخمها و تخریب بافتها در نتیجهی کافی نبودن جمعیت سلولی میشود.
بهرهبرداری از پتانسیل کامل آنزیم تلومراز
درک تنظیمات و محدودیتهای آنزیم تلومراز امکان معکوس کردن روند کوتاه شدن تلومرها و پیر شدن سلولها فراهم میسازد و در نتیجه میتواند منجر به افزایش طول عمر انسان و بهبود سلامتی و تندرستی افراد مسن شود. تحقیقات انجامشده در آزمایشگاه چن و همکارانش اخیرا مرحلهای حیاتی در چرخهی کاتالیستی تلومراز کشف کرده است که این مرحله توانایی آنزیم تلومراز را برای سنتز تکرارهای DNA تلومریک در انتهاهای کروموزومها محدود میکند. پروفسور چن گفت:
تلومراز یک سیستم ترمز داخلی برای تضمین این که سنتر تکرارهای DNA تلومریک دقیق و بدون خطا انجام شود، دارد. اگرچه این ترمز محافظتی فعالیت کلی آنزیم تلومراز را نیز محدود میکند. پیدا کردن راهی برای رها کردن درست این ترمز روی آنزیم تلومراز امکان بازیابی طول از دست رفتهی تلومر در سلولهای بنیادی بالغ و حتی معکوس کردن پیر شدن سلول را فراهم میکند.
منظور از ترمز ذاتی آنزیم، یک سیگنال توقفی است که درون الگوی RNA خود آنزیم قرار گرفته است و پیغام توقفی برای عمل آنزیم محسوب میشود. زمانی که تلومراز سنتز DNA را برای تکرار بعدی آغاز میکند، این سیگنال توقف هنوز فعال است و سنتز DNA را محدود میکند.
با هدف قرار دادن سیگنالی که از آغاز تکرار دوباره سنتز DNA جلوگیری میکند، عمل آنزیم تلومراز را میتوان در جهت جلوگیری از کوتاه شدن تلومر تحریک کرد و موجب جوان شدن دوبارهی سلولهای بنیادی بالغ شد.
بیماریهای انسانی نظیر دیس کراتوز مادرزادی (dyskeratosis congenita)، کم خونی آپلاستیک (aplastic anemia) و فیبروز ریوی ایدیوپاتیک (idiopathic pulmonary fibrosis)، از لحاظ ژنتیکی با جهشهایی که دارای تأثیر منفی روی فعالیت تلومراز هستند یا در سرعت بخشیدن کاهش طول تلومر نقش دارند، مرتبط بودهاند. نتیجهی کوتاه شدن سریع تلومرها پیری زودرس و افزایش تخریب ارگانها و کم شدن طول عمر بیمار در نتیجهی کافی نبودن جمعیت سلولی است. افزایش فعالیت تلومراز امیدوار کننده ترین راه درمان این بیماریها است.
با این که افزایش فعالیت تلومراز میتواند جوانی را به سلولهای پیر هدیه دهد و بیماریهای پیری زودرس را درمان کند، ولی این جا یک مشکلی هم وجود دارد. همانطور که سلولهای بنیادی جوان از تلومراز برای جبران کاهش طول تلومر استفاده میکنند، سلولهای سرطانی نیز برای حفظ رشد نابهجا و مخرب خود از تلومراز استفاده میکنند. تقویت و تنظیم عمل تلومراز باید با دقت انجام شود و روی خط باریکی بین جوانسازی دوباره سلولها و بالاتر شدن خطر رشد سرطان حرکت کند.
بقیهی سلولهای بدن، یعنی سلولهای بدنی که عمدهی سلولهای بدن را تشکیل میدهند دارای فعالیت تلومراز نیستند. از آنجایی که تلومراز رشد کنترلنشدهی سلولهای سرطانی را تحریک میکند، این ویژگی سلولهای بدنی انسان خطر رشد سرطان را کاهش میدهد. بر این اساس داروهایی که فعالیت تلومراز را در همهی سلولها بدون هیچ تمایزی افزایش میدهند، مطلوب نیستند. برای تقویت دقیق فعالیت تلومراز بهصورت انتخابی در سلولهای بنیادی بالغ، این کشف نشان میدهد مرحله حیاتی در چرخهی کاتالیستی تلومراز هدف مهم داروی جدید است. داروهای کوچک مولکولی برای افزایش فعالیت تلومراز به صورت اختصاصی در سلولهای بنیادی برای درمان بیماری و همچنین درمانهای ضد پیری بدون افزایش خطر ابتلا به سرطان میتواند طراحی شود.